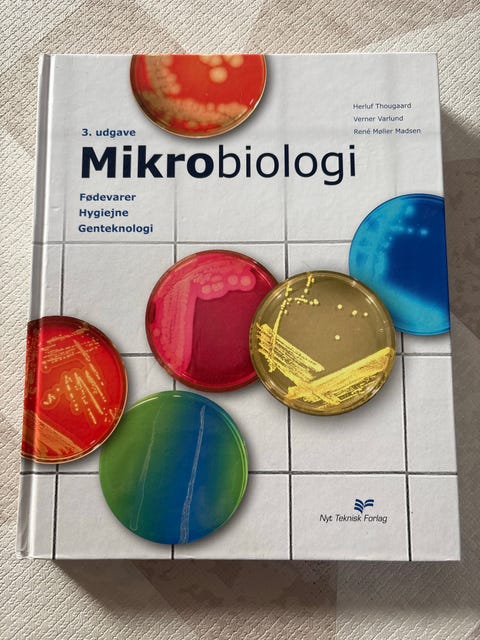

Solrød Strand2 dage

Køb alt brugt til underholdning og hobby på DBA. Lige nu har DBA 2.278 annonce(r), der sælger hobbyudstyr.
Hobbyer giver voksne og børn mulighed for at slappe af, udvikle sig og opdage nye aspekter af sig selv. For eksempel er et musikinstrument et dyrt køb, og især en nybegynder kan ofte finde et brugt musikinstrument, der passer til deres behov. Du kan også finde brugte ting til forskellige former for håndarbejde, og det er en god måde at genbruge og komme af med tråde, stoffer og andet materiale, som du ikke længere har brug for.